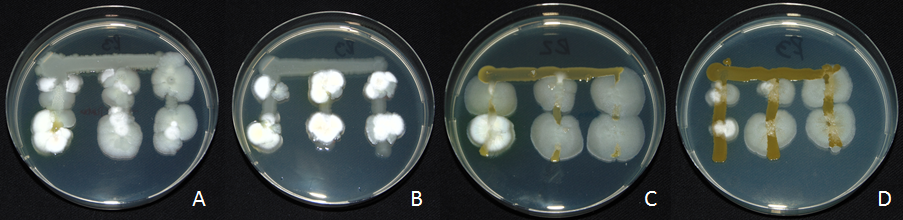

By: Luis Romero/Subgerente técnico – bio insumos nativa
En Chile, especies frutales como el nogal, el avellano, el cerezo el kiwi enfrentan amenazas constantes de bacterias fitopatógenas como Xanthomonas arborícola (Xac y Xaj). and Pseudomonas syringae. (Pss y Psa) ocasionando daños de tipo atizonamiento, muerte de ramillas, manchas foliares y exudados entre otros. La estrategia de manejo convencional se basa en buena parte con programas fitosanitarios preventivos con productos químicos en base a cobre (Cu++) que si bien, han resultado fundamentales en la estrategia de manejo de las bacteriosis, su uso desmedido ha generadodesequilibrios en la microbiología edáfica, alteraciones de la filósfera de las plantas y también favorece la aparición de especies resistentes o con pérdida de sensibilidad a cobres. Por otro lado, a raíz de todos los efectos adversosmencionados podemos entender que las normativas internacionales opten por limitar su uso, tanto en dosis como en número de aplicaciones debido a riesgos ambientales y/o posibles implicancias a la salud humana.
2. Perdida de sensibilidad and mecanismos de adaptación
Entendiendo el peligro que conlleva la perdida de sensibilidad a cobres, en estas especies fitopatógenas, podemos mencionar dos mecanismos distintos entre sí que juegan un rol predominante en ello. El primero corresponde a cepas patógenas que han logrado generar cambios heredables (mutaciones) que se traspasan a las generaciones posteriores, que posteriormente en aplicaciones sucesivas en este caso de cobre, ejercen presión de selección de aquellas especies con este factor mutagénico heredable por sobre aquellas que no lo poseen. El otro mecanismo que poseen estas bacterias (Pseudomona syringae and Xanthomonascampestris), corresponde a capacidad formadora de biofilms, que una asociación en comunidades bacterianas se embeben en una matriz extracelular de exopolisacaridos que actúa como barrera física que además de permitirle adherirse a las superficies, la protege de la desecación, de radiación UV yno menos importante protección de los agentes antimicrobianos (Cu++, antibióticos), permitiéndoles ser hasta 1,000 veces más resistentes a los tratamientos químicos que las bacterias en estado libre (Olsen, 2015).
3. Situación en chile y manejo integrado
La situación de chile no está exenta de problemas, estudios en la región de O’higgins muestran acumulaciones alarmantes en los suelos y en tejidos de cobre para varias especies frutícolas y en muchos casos por sobre los limites aceptados según normativa europea 30 mg/kg (Auger, 2022). En el caso específico de aparición de perdida de sensibilidad para el caso de nogales se reportan los primeros antecedentes el año 2000 con estudios sobre Xanthomonas campestris pv. Juglandis (Agurto, Esterio & Auger, 2000) y másrecientemente incrementos en las concentraciones letales de Cu++ en especies de Xanthomonas arborícola pv. Juglandisen la región del Biobio de hasta 1.000 µg de ión cobre por mL-1 (Moya et al, 2018), la situación respecto de pseudomonas ya a finales de la década del 90’s se sugieren antecedentes de incrementos en las tolerancias por parte de Pseudomonas syringae pv. syringae (Scheck & Pscheidt, 1998) y hoy en día el panorama no parece ser muy alentador ya que cerca del 95% de las cepas de Pseudomonas spp.asociada a los síntomas de cancro bacteriano en la zona productora de cerezos de la Región O’Higgins mostró resistencia a la concentración mínima inhibitoria (CMI) desulfato de cobre (CuSO4) (Beltran et al, 2021), esta situación no solo se encuentra restringida a frutales también existe evidencia de resistencia en cultivos como el tomate donde Clavibacter michiganensis agente causal del cancro bacteriano del tomate presento niveles medios de tolerancia a las concentraciones de cobre (Valenzuela et al, 2026). Dado esta situación preocupante existe consenso en que la forma de abordar estas patologías debe incorporar un manejo integrado a fin de minimizar la probabilidad de incremento de especies resistentes a cobre, donde el manejo integradocon labores culturales y rotación de activos químicos, biológicos y/o elicitores parecen ser una alternativapromisoria.
3.1 Uso de cobres como, cuando y con que complementarlo: El uso de cobres en sus diversas formulaciones está ampliamente extendido en frutales de carozo, kiwis, nogales y avellanos, primero hay que diferenciar entre óxidos e hidróxidos de cobre de los sulfatosde cobre, estos últimos poseen un efecto potente rápido, pero más corto y un posible riesgo de fitoxicidad que no se puede dejar de lado, por lo que intuitivamente entendemos el momento de uso de cada uno. Respecto de su forma de acción hay que recordar que ambos tipos poseen efecto de contacto-protectante en el tejido, es decir actúan en superficie provocando control de las poblaciones epifitas mientras se encuentre la concentración letal del ión Cu++, con lo cual se hace imperante un efecto más amplio que podría estar dado por elicitores o inductores de resistencia en momentos que los últimos se puedan aplicar (metabolismo activo). Respecto de cuando, se ha visto que aplicacionessegún calendario de cobres incrementan el riesgo de aparición de poblaciones con pérdida de sensibilidad, esto no significa prescindir de la herramienta, significa que su uso debe ser racional y con riesgo real de infección, para ello el conocimiento de la dinámica poblacional en base a condiciones atmosféricas puede entregar información precisadel momento de uso bajo cada condición particular (Donoso et al, 2020). Estas mismas consideraciones son válidas para los antibióticos, que actúan de forma más menos similar, sin embargo, el mecanismo de acción mucho más específico en antibióticos (sitio de acción) poseen una capacidad de adaptación mutagénica mayor al mismo cobre, por lo cual su uso se encuentra más restringido a eventos particulares de riesgo y momentos específicos como la floración en cerezo. Bajo estos conceptos restrictivos, la rotación en modo de acción se hace indispensable no solo ante problemas de perdida de sensibilidad, también en aspectos de mejoría global del programa fitosanitario, particularmente herramientas biológicas de control, como Nacillus (Bacillus spp. y Brevibacillus spp) han mostrado una excelente sinergia en rotación con cobres y el alternar controladores biológicos con cobre parece ser más adecuado, respecto del uso exclusivo del compuesto metálico (Lemus, 2021), su efecto es en gran parte debido a su formulación multicepa deactividad principalmente colonizadora y por competencia por nutrientes. No obstante, esta capacidad no solo se queda en la colonización y uso de recursos, también es capaz de degradar activamente el biofilm, generado por las especies patógenas tanto de Pseudomonas as Xanthomonas con niveles de control alrededor del 85% de la estructura en cuestión, estos bacillus crecen sobre el biofilm bacteriano y logran romper la barrera de la matriz de exopolisacaridosque la protegen (fig. 1), atacando directamente uno de los factores implicado en la resistencia a cobres aumentando la susceptibilidad de estas bacterias a otros tratamientos, facilitando su eliminación. Por otra parte, también existen antecedentes del uso de productos biológicos utilizados en programas de uva de mesa donde los valores EC50 , de los ingredientes activos evaluados tienden a ser menores en las poblaciones del patógeno debido a que el biocontrolador rompe en parte la presión de selección ejercida por el químico ya que su efecto es indistinto tanto para especies sensibles como con pérdida de sensibilidad.
Fig. 1: Crecimiento de las diferentes concentraciones del producto Nacillus WP sobre sobre líneas sembradas de las bacterias A) Pseudomona syringae pv. syringae; B) Pseudomona syringae pv. actinidiae; C) Xanthomonas arborícola pv. juglandis cepa 1 (Huaqui) y D) cepa 2 (Negrete), después de 96 horas de incubación.
Otros mecanismos de acción complementaria corresponden al uso de inductores de la resistencia, en este ámbito existen elicitores que promueven la activación del sistema de defensa propio de las plantas, en esta línea existen productos como acibenzolar-s-metil de amplio uso en kiwis y un formulado en base a Pseudomonas Protegens de nombre comercial Taniri que posee un mecanismo de activación de genes asociados a mecanismos de defensa contra infecciones de bacterias patógenas, complementando el ciclo para un control que fomenta menor riesgo de adaptaciones de las bacterias patógenas. Por último, no dejar de lado las labores culturales de remoción de fuentes de inoculo (plantas enfermas, curación de cancros y podas sanitarias) que ayudan a disminuir drásticamente la capacidad infectiva al remover los elementos implicados en la diseminación para nuevos puntos de infección. En síntesis los programas con incorporación de rotación de activos, uso racional de cobres, manejos culturales y/o herramientas complementarias como los elicitores han demostrado efectos positivos en la performance global del manejo, en kiwis por ejemplo contra PSA el uso de un programa base a cobre (yema hinchada, brotación y crecimiento) más antibióticos de refuerzo con elicitores en floración versus un programa mixto que aplica rotación de cobres y Nacillus más el uso de Taniri en floración logro reducciones interesantes en los niveles de tizón de flor y botones florales, atribuibles al patógeno Pseudomona syringae pv. Actinidiae con la posterior mejora en la oferta frutal del cultivo.

Fig. 2: Porcentajes de botones florales y flores atizonadas en kiwi Hayward en dos localidades de la región del Maule. valores en columnas de un mismo color, seguidas por igual letra no difieren estadísticamente (p<0,05).
Estos datos obtenidos de programas mixtos aplicados en kiwis ratifican la evidencia de mejoría de huertos al realizar la incorporación de Nacillus – Taniri en el manejo de las bacteriosis y estas mejoras estarían dadas en parte a la interacción con especies con pérdida de sensibilidad o agrupadas en biofilms bacterianos. Sin perjuicio de lo anterior, en tanto nos nutramos de la información disponible plasmándola en programas con incorporación de diversas herramientas químicas y/o biológicas, bien posicionadas se podría frenar e incluso revertir la aparición de especies con pérdida de sensibilidad o derechamente resistencia tanto a cobres como antibióticos, con lo cual la transición hacia una agricultura sostenible debería incorporar estas herramientas biológicas o tecnológicas no solo en aspectos de disminución de la carga química de la fruta sino que también como actores principales en el combate las resistencias que son una realidad incomoda en nuestros frutales y cultivos.
Bibliografia consultada:
Olsen, I. Biofilm-specific antibiotic tolerance and resistance. Eur J Clin Microbiol Infect Dis 34, 877–886 (2015).
Moya-Elizondo, E., Auil, P., Oyarzúa, P., & Gerding, M. (2018). Resistencia al ión cobre de xanthomonas arboricola pv. juglandis en nocedales de la región del Biobío. Chilean journal of agricultural & animal sciences, 34(1), 3-11.
Auger Saavedra, J. (2022). Informe Final Proyecto FIC Región Libertador General Bernardo O’Higgins/Laboratorio de Fitopatología Frutal y Molecular: «Transferencia Manejo para frutales contaminados por cobre» (COD IDI 40008890-0). Facultad de Ciencias Agronómicas, Universidad de Chile.
Agurto G., L., Esterio G., M., & Auger S., J. (2000). La resistencia al ión cobre en bacterias fitopatógenas en Chile.
Scheck, H. J., & Pscheidt, J. W. (1998). Effect of copper bactericides on copper-resistant and -sensitive strains of Pseudomonas syringae pv. syringae. Plant Disease, 82(4), 397-406.
Beltrán, M. F., Osorio, V., Lemus, G., Millas, P., France, A., Correa, F., & Sagredo, B. (2021). Bacterial community associated with canker disease from sweet cherry orchards of central valley of Chile presents high resistance to copper. Chilean Journal of Agricultural Research, 81(3), 378–392.
Donoso, E., Caballero, J. M., Hettich, W., García, C., Romero, L., Venegas, R., & Bugueiro, M. (2020) En huertos de cerezo. Estrategia de manejo de cáncer bacterial invernal en base a información epidemiológica.
Lemus S., G., & Rayentué, I. d. I. A. C. R. d. I. (2020). Cáncer Bacterial del Cerezo: Epidemiologia de la enfermedad y estrategias de control.
Lemus S., G. (2021-08) Avances en la situación sanitaria del cerezo. Santiago, Chile: Redagrícola, no. 121 (p. 38-40). (3 p.) https://hdl.handle.net/20.500.14001/68806
Valenzuela, M., Vásconez, I.N., Méndez, V., Fuentes, B., Altimira, F., Valdés, F., Montenegro, I., Besoain, X. and Seeger, M. (2026), Copper resistance and genetic determinants in Chilean strains of Clavibacter michiganensis the causal agent of bacterial canker of tomato. Pest Manag Sci. https://doi.org/10.1002/ps.70665









